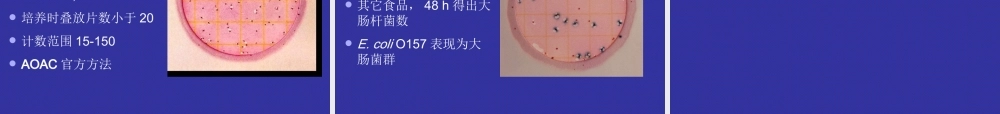
大肠杆菌PPT.ppt

大肠菌群类检测方法介绍大肠菌群大肠菌群(Coliform)(Coliform)粪大肠菌群(FecalColiform)大肠杆菌(E.coli)肠杆菌科(Enterobactericeae)肠杆菌科四种指标菌的范围肠杆菌科四种指标菌的范围(隶属关系)(隶属关系)肠杆菌科四种指标菌的范围肠杆菌科四种指标菌的范围(隶属关系)(隶属关系)食品中大肠菌群类及其检验食品中大肠菌群类及其检验●大肠菌群(coliforms):◆指一群在36℃条件下培养48h能发酵乳糖、产酸产气的需氧和兼性厌氧革兰氏阴性无芽胞杆菌。◆该菌群主要来源于人畜粪便,故以此作为粪便污染指标来评价食品的卫生质量,推断食品中有否污染肠道致病菌的可能。●粪大肠菌群(Faecalcoliform):◆系指一群在44.5℃培养24h~48h能发酵乳糖、产酸产气的需氧和兼性厌氧革兰氏阴性无芽胞杆菌。●大肠杆菌(Escherichiacoli):◆大肠杆菌广泛存在于是人和温血动物的肠道中,能够在44.5℃发酵乳糖产酸产气、IMViC生化试验为++--或-+--。◆包括:产肠毒素(ETEC)肠致病性(EPEC)肠侵袭性(EIEC)肠出血性(EHEC)主要菌型:O157:H7大肠菌群类检测方法大肠菌群类检测方法•GB•SN•日本方法•VRB固体平板法•Deso固体平板法•显色培养基法•3MPetrifilm测试片法MPNTable革兰氏染色24±2h44.5±0.5℃粪大肠菌群检测的GB法乳糖胆盐发酵管产气的培养物EC肉汤不产气粪大肠菌群阴性产气EMB平板18-24h有典型菌落报告为阳性36±1℃back44.5±0.5℃IMVICback营养琼脂斜面18-24hbackbackbackback法国标准化协会(AFNOR)认证美国农业部(USDA)认证美国食品和药品管理局(USFDA)认证美国食品安全与检测机构(USDAFSIS)认证日本食品安全法规标准分析方法北美国家认证加拿大健康保护协会认证澳大利亚和新西兰食品安全认可方法波兰标准化委员会(PKN)认证智利农业部(SAG)认证中国的GB和SN即将发布实施国际官方方法国际官方方法3M测试片法检测食品中大肠菌群和大肠杆菌3M测试片法检测食品中大肠菌群和大肠杆菌3MPetrifilm3MPetrifilmTMTM大肠杆菌大肠杆菌//大肠菌群大肠菌群测试片测试片的检测原理的检测原理-葡萄糖苷酶四唑翁指示剂四唑翁指示剂((ttrazoliumrazolium))-半乳糖苷酶薄膜粘合剂+指示剂冷水可溶性凝胶标准培养基+冷水可溶性凝胶粘合剂印有格子的纸片大肠菌群及大肠杆菌3MPetrifilm检测法接种1ml样品匀液到每张PetrifilmTM大肠菌群测试片计数红色带气泡的菌落报告大肠菌群数36C1C检样25g(mL)样品+225mL稀释液只检测大肠...